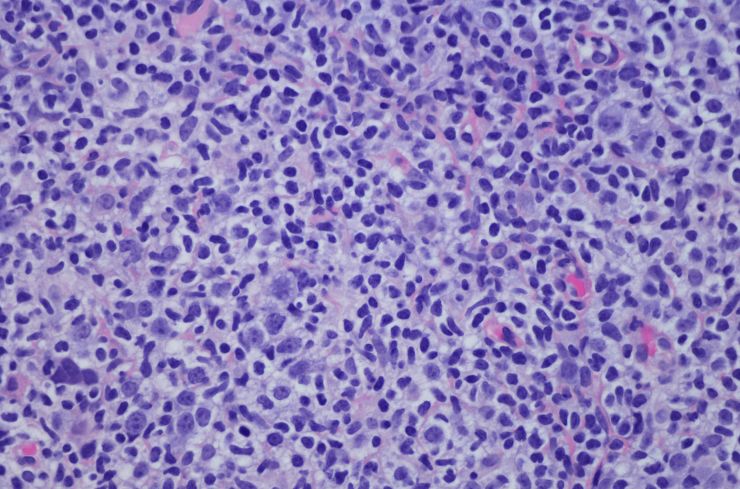

Bono Marzo 2026: Revisa fechas de pago y cómo recibir los $66.834 del Aporte Familiar Permanente
Este beneficio estatal entrega un monto por carga familiar o por familia, según corresponda, y no requiere postulación. ¿Quiénes son los beneficiarios y cuándo se pagará? Conoce todos los detalles acá.
13/02/2026